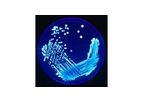
Legionella Analysis

- Home
- Companies
Refine by
Industries served
- Monitoring and Testing
- Environmental
- Agriculture
- Water and Wastewater
- Soil and Groundwater
- Health and Safety
- Chemical & Pharmaceuticals
- Air and Climate
- Energy
- Manufacturing, Other
- Food and Beverage
- Construction & Construction Materials
- Medical / Health Care
- Waste and Recycling
- Oil, Gas & Refineries
- University / Academia / Research
- Plastics & Resins
- Textile
- Automobile & Ground Transport
- Aerospace & Air Transport
- Packaging
- Government
- Defense
- Paint
- Pulp & Paper
- Mining
- Metal
- Maritime/Shipbuild/Water Transport
- Electronics and Computers
- Forestry & Wood
- Banking & Finance / Insurance / Legal
- Dry Cleaning
- Domestic
- Glassware
- Retail
- Printing
- Real Estate
Environmental Industry Laboratory
221 companies found

Laboratorybased inLondon, ONTARIO (CANADA)
A&L Canada Laboratories Inc.(A&L) was formed in 1985 with the merger of Croptech Laboratories. The new corporation is a wholly owned Canadian subsidiary of A&L Laboratories which consists of eight analytical laboratories regionally located ...
A laboratory package containing 96 soil test probes for performing the CO2-Burst procedure.Order required filters, beakers and jars ...
Laboratorybased inIndianapolis, INDIANA (USA)
AIHA Accredited Laboratory - Asbestos Abatement Projects - Work Area Monitoring & Onsite - - Asbestos Training Courses - Health & Safety Programs - Hazard Communications Programs Personal Protective Equipment programs - Respiratory Protection ...
ACT performs limited and comprehensive lead-in-paint investigations and risk assessments in which all painted surfaces observed throughout a building are documented and sampled for the presence of, or assumed to contain lead, depending on the ...
Laboratorybased inRedmond, WASHINGTON (USA)
OnSite Environmental Inc. (OnSite), is a full service environmental laboratory that has been providing analytical testing services. We specialize in the chemical analyses of soil, sediment, water, air, and hazardous waste samples. OnSite provides ...

Laboratorybased inGuelph, ONTARIO (CANADA)
Agri-Food Laboratories Inc. is a full service analytical facility located in Guelph, Ontario, serving Canadian and international clients since 1984. We offer high quality, reliable services providing Measurements for Management to all sectors of the ...

Laboratorybased inChelmsford, MASSACHUSETTS (USA)
We specialize in isotope analyses for researchers in the fields of geology, economic geology, geochronology, archaeology, anthropology, and hydrology, and for environmental, metabolic, and food adulteration studies. Geochron Laboratories has been ...

Laboratorybased inRichmond, CALIFORNIA (USA)
Berkeley Analytical (BkA) is an environmental laboratory specializing in the analysis of organic chemicals emitted by and contained in building products, finishes, furniture, medical devices, and consumer products such as toys. We provide ...
Laboratorybased inRaleigh, NORTH CAROLINA (USA)
Research Triangle Park Laboratories, Inc. are dedicated to technical excellence, high quality analytical support, and customer satisfaction. We have an established client base of over 200 companies and over 35 years of experience in analytical ...
US and Foreign Imported Products Testing for Contamination, Toxic Chemicals, Pesticides, VOCs; Banned Substances; Product Purity. Indoor Air, Ambient & Sources (Stack Gases), VOC Vapor Intrusion, Dissolved Gases in Groundwater, Landfill Gases, ...

Laboratorybased inDulles, VIRGINIA (USA)
Our services include a complete range of sampling and analysis of indoor environments for bioaerosols, and the identification of biological sources of IAQ problems. In addition to a full range of microbial culture analysis, our microbial services ...
Legionella is a bacterium that is the agent of Legionnaire"s disease and Pontiac fever. It is primarily caused by Legionella pneumophila and is one of the most challenging building acquired diseases in the industrial hygiene community. According to ...

Laboratorybased inVerona, WISCONSIN (USA)
Farmer-owned and client focused, we are dedicated to providing comprehensive laboratory analysis, record management and information services. From DHI to soil testing, AgSource and AgSource Laboratories offer valuable data and superior customer ...
Growers should use soil testing as a management tool for making scientifically sound management decisions about their soil fertility program. A fertility management program based on information from soil test results can benefits the farmer in many ...

Laboratorybased inRedruth, UNITED KINGDOM
We're based in Cornwall, in purpose-built, state-of-the-art microbiology and asbestos laboratories. In addition to this, however, we have asbestos consultants based in Plymouth and Taunton with mobile laboratories. This means we're able to provide ...
Our UKAS-accredited, asbestos bulk testing services are carried out in accordance with ISO/IEC 17025: 2005. Using stereo microscopy, polarised light microscopy and dispersion staining to test bulk samples, everything we do, not only complies with ...

Laboratorybased inBellingham, MASSACHUSETTS (USA)
Jordi Labs provides the highest quality analytical services, polymer based HPLC columns and packing media in the industry. As a family company, we take pride in the production of each of our products. Customers in nearly all industries are currently ...
Jordi Fluorinated resin is a 100% divinylbenzene phase with a surface coating formed with fluorinated benzene rings. This patented technology provides decreased absorbance as compared to non-bonded DVB surfaces and is a good option for applications ...

Laboratorybased inGent, BELGIUM
Normec OWS offers lab and consulting services to various clients from the public and private sector. We help our clients with consulting services in the field of biodegradation and compostability, waste management and related legislation in both ...
Specific consumer products, such as detergents or flushable wipes and refills, can inevitably end up in a fresh water environment. Biodegradability of these products helps to prevent any kind of damage to the ecosystem. Normec OWS offers different ...
Laboratorybased inTraverse City,, MICHIGAN (USA)
GLEC with headquarters in Grand Traverse county in Michigan and a facility in Columbus Ohio has extensive capabilities and experience in conducting field and laboratory tests required by environmental legislation such as the Toxic Substances Control ...
Biological surveys are often required to achieve compliance with a variety of federal and state regulations. At GLEC we have the experienced staff, the equipment, and the resources necessary to conduct effective biological surveys to meet a variety ...

Laboratorybased inElmsford, NEW YORK (USA)
EAS is an independent environmental and industrial hygiene laboratory in business since 1985. Eastern Analytical Services, Inc. was established with the intent of providing quality analytical services within the Asbestos Abatement Industry. Since ...
As you're probably aware, lead poisoning has become a major concern to families living in homes constructed prior to 1980. Children exposed to lead may suffer irreparable learning disabilities, impaired hearing, hyperactivity, decreased growth, and ...
Laboratorybased inPennant Hills, AUSTRALIA
SESL Australia was established in 1983 as Sydney Environmental & Soil Laboratory by Simon Leake. SESL provides independent laboratory testing and advisory services to landscape, horticulture, sport and leisure turf, civil construction, environment, ...
Contaminated Site Investigations, Remedial Action Plans for Contaminated Sites, Waste management and waste classifications, Risk assessment, Asbestos investigations, Assessment of the effect of waste disposal, recycling and reuse according to the ...

Laboratorybased inInglewood, CALIFORNIA (USA)
ProteoGenex is an established, innovative provider of biological specimens and clinical information of the highest quality standards. We are a privately held US company founded in Los Angeles, CA in 2003. With headquarters in Los Angeles, CA, we ...

Laboratorybased inGuelph, ONTARIO (CANADA)
Lactanet Canada is a producer owned organization, providing innovative dairy herd management and genetic services to more than 8,000 dairy farm customers and professional advisors throughout the country. We are a national company created by a ...
Laboratorybased inSandy Hook, CONNECTICUT (USA)
Willow Environmental, LLC. is a full service environmental testing company. Some of our services include: lead paint XRF inspections, mold and indoor air quality testing, asbestos inspections, radon testing, water testing, ...
Many building components may contain asbestos, such as insulation, floor tiles, mastic roofing, and sidings. When disturbed or damaged, asbestos can cause significant health threats. Willow is licensed and trained to inspect and obtain samples for ...

Laboratorybased in, UNITED KINGDOM
Applied Genomics are a UK-based consultancy that provide innovative DNA-based solutions for improving ecological assessments. Our environmental DNA (eDNA) analyses deliver data-driven insights for deeper due diligence and more meaningful risk ...
For establishment of ecological baselines and ongoing monitoring of biological communities. Environmental DNA analysis provides responsive, cost-effective biodiversity monitoring for understanding the ecological state, stability and productivity of ...

Laboratorybased inGurgaon, INDIA
Avigene is a young and technologically progressing organization with focus on Avian DNA testing. Avigene’s lab team has dedicated experience in the field of molecular biology specific to development of DNA based research methodologies that find ...
Bird DNA testing would not have its benefits without proper bird identification. Recognizing this need Avigene introduced premium quality bird rings/ leg bands. A wide range of sizes are available covering all bird species. It is important to ring ...